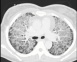

Oncology – non-small cell lung cancer (NSCLC)
Introduction
Lung cancer remains among the commonest form of cancer in both males and females in Ireland with over 2,500 new cases each year. Unfortunately, a large portion of patients present with inoperable advanced disease and in patients with curable lung cancer – even after surgery, radiotherapy and...
Read more